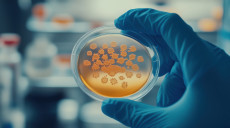
Labor_Mikrobiology_Frau_lacht

Leitung medizinisches Labor (m/w/d) für 2 Laborstandorte in Nordrhein-Westfalen
Kennziffer, Chiffre: GADn1225CA28_GP2365
Im Auftrag unseres Partners suchen wir einen
Facharzt für Laboratoriumsmedizin (m/w/d)
für die standortübergreifende Leitung zweier Großlabore in Nordrhein-Westfalen
Sie sind Facharzt (m/w/d) für Laboratoriumsmedizin und suchen eine neue Herausforderung in einem modernen, international agierenden Unternehmen? Unsere Laboratorien für klinische Diagnostik bieten ein breites Spektrum an Testdienstleistungen – von Routineuntersuchungen bis hin zu hochspezialisierten genetischen Analysen.
Innerhalb der Unternehmensgruppe liegt der Fokus auf mehr als 2.000 verschiedenen Analysen in den Bereichen Labormedizin, medizinische Mikrobiologie, Molekulardiagnostik, Humangenetik und Krankenhaushygiene.
Als ärztlicher Leiter (m/w/d) übernehmen Sie die fachliche und disziplinarische Führung der Labormedizin sowie der Mikrobiologie und Virologie an zwei Laborstandorten. Sie leiten ein interdisziplinäres Team und gestalten aktiv die Weiterentwicklung des Fachbereichs.
Neben einer modernen technischen Ausstattung erwarten Sie attraktive Arbeitsbedingungen, umfangreiche Weiterbildungsmöglichkeiten sowie zahlreiche Mitarbeitervorteile.
Ihre Vorteile:
• Sicherer Arbeitsplatz in international agierender Unternehmensstruktur
• Familiäres Umfeld
• Abwechslungsreiche Tätigkeit bei einem wachsenden Gesundheitsanbieter
• Individuelle Förderung, bei Interesse Standortleitung
• Jobrad, Firmenwagen auf Anfrage/Bahncard 100
• Krankenhauszusatzversicherung, Zuschuss zum ÖPNV, betriebliche Altersvorsorge
• Vielfältige Mitarbeitervorteile, z. B. Vergünstigungen bei Sport-/Fitnessangeboten
• Bildschirmarbeitsplatzbrille
• Flexible Arbeitszeiten
• Team-Events, lokale Running-Events
• Attraktive Zuschläge für Wochenend-, Feiertags- und Nachtarbeit (wenn relevant)
• Möglichkeit zur Beteiligung an Forschungsaufgaben und Studien
Ihre Aufgaben:
• Ärztliche Bereichsleitung sowie fachliche und disziplinarische Verantwortung für den Bereich
Mikrobiologie
• Erstellung medizinischer Befunde in allen Bereichen der fächerübergreifenden
labormedizinischen Diagnostik
• Beratung und Unterstützung der Einsender
• Kontinuierliche Weiterentwicklung des Instituts
• Zusammenarbeit mit einem interdisziplinären ärztlichen Team
• Anleitung der MTLAs
• Beratung von Fachkollegen zur medizinischen Indikationsstellung und Befundinterpretation
• Schulung und Anleitung des Laborpersonals
• Umsetzung und Unterstützung der Qualitätsstandards
• Etablierung fachlicher Schwerpunkte
Unsere Anforderungen:
• Abgeschlossene Facharztanerkennung für Laboratoriumsmedizin
• Fachliche Expertise in modernen labormedizinischen Verfahren oder
Spezialisierung in einem bestimmten Bereich
• Hohe Sozial- und Führungskompetenz, idealerweise Leitungserfahrung
• Teamfähigkeit und bereichsübergreifende Kooperationsfähigkeit
• Interesse an interdisziplinärer Zusammenarbeit
• Hohes Verantwortungs- und Qualitätsbewusstsein
• Selbstständige und strukturierte Arbeitsweise
• Organisationsgeschick und Eigeninitiative
• Interesse an der Dienstleistungstätigkeit
• Sehr gute Deutsch- und gute Englischkenntnisse
Dann berichten wir Ihnen gerne in einem persönlichen Gespräch mehr über Ihre Möglichkeiten und Ihre Chancen. Rufen Sie uns an oder senden Sie uns eine E-Mail um ein unverbindliches Beratungsgespräch zu vereinbaren.
Wir freuen uns auf Sie, Ihre Fragen beantwortet gerne:
Deutschland
Metropolregion - NRW
Vollzeit
Für diese Funktion wird eine der anspruchsvollen Tätigkeit entsprechende leistungsgerechte Vergütung angeboten.
GOING INTERNATIONAL
information services G. Polak KG
Fasangasse 28/27
A-1030 Vienna
Tel.: +43-(0)1-798 2527 15
Fax.: +43-(0)1-798 2527 11
E-Mail: office@goinginternational.org
Falls Sie spezielle Wünsche an Ihren künftigen Arbeitgeber oder Ihre künftige Position haben, bitten wir Sie, uns dies mitzuteilen. Im Laufe des Beratungsprozesses berücksichtigen und kommunizieren wir diese gerne.
Senden Sie uns Ihren tabellarischen Lebenslauf und Ihr Anschreiben sowie Ihre Ausbildungs- und Weiterbildungsnachweise und Ihre Zeugnisse zu.
Alle Ihre Angaben und Unterlagen behandeln wir selbstverständlich streng vertraulich.
Einblick